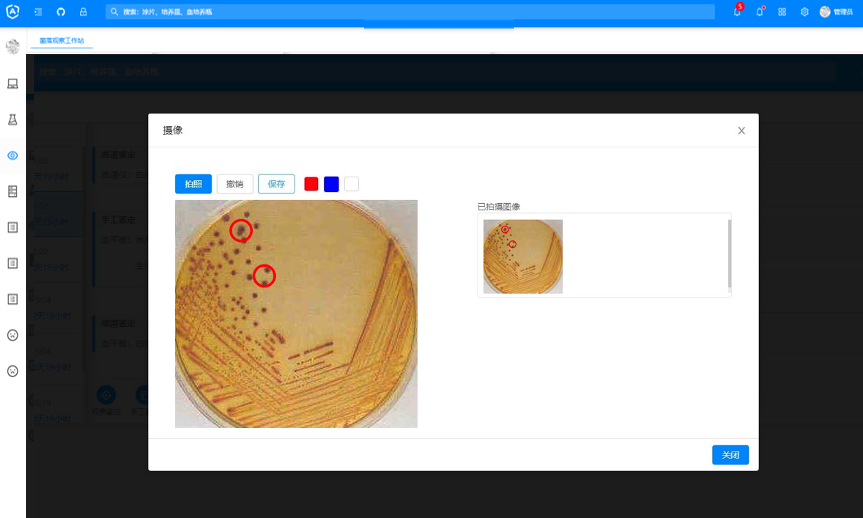
微信圖片_20220505110817.png

打開手機(jī)掃描二維碼
即可在手機(jī)端查看
臨床微生物檢驗(yàn)是為感染性疾病提供微生物學(xué)診斷,以控制和預(yù)防傳染病的擴(kuò)散,注重如何從臨床標(biāo)本中分離出病原微生物,并正確鑒定及快速發(fā)出檢驗(yàn)報(bào)告。
臨床微生物檢驗(yàn)過程復(fù)雜,檢驗(yàn)周期長(zhǎng),包括簽收、接種、培養(yǎng)、鑒定、上機(jī)等操作,且需要對(duì)該鏈路中每個(gè)節(jié)點(diǎn)進(jìn)行詳細(xì)記錄,用于指導(dǎo)診斷,以及追溯歷史。然而,當(dāng)前大部分醫(yī)院還在使用紙質(zhì)化的記錄。

紙質(zhì)化記錄存在如下的缺點(diǎn):
① 記錄由多人寫成,每人記錄習(xí)慣,筆跡不同,內(nèi)容標(biāo)準(zhǔn)不一。
基于十余年對(duì)微生物檢驗(yàn)領(lǐng)域信息化建設(shè)的沉淀,同時(shí),經(jīng)過與眾多微生物專家的多輪深入交流,歷時(shí)數(shù)年,精心打磨了聚合專業(yè)化、智慧化的全流程無紙化過程記錄的微生物檢驗(yàn)信息系統(tǒng)。該信息系統(tǒng),深入挖掘用戶工作場(chǎng)景,對(duì)微生物檢驗(yàn)過程記錄的各個(gè)節(jié)點(diǎn)進(jìn)行專業(yè)、規(guī)范記錄,必要節(jié)點(diǎn)可進(jìn)行拍照留存,同時(shí),對(duì)違反相關(guān)標(biāo)準(zhǔn)的情況,進(jìn)行智慧化提示。
全流程無紙化過程記錄
樣本簽收
標(biāo)本簽收時(shí),記錄簽收時(shí)間,登記標(biāo)本狀態(tài);對(duì)于不合格標(biāo)本,記錄不合格原因,拒收不合格標(biāo)本,同時(shí),支持對(duì)不合格標(biāo)本進(jìn)行拍照留存,可以更直觀對(duì)標(biāo)本狀態(tài)進(jìn)行補(bǔ)充說明(比如:血培養(yǎng)瓶采血量不足,標(biāo)本滲漏等等);特殊情況需要讓步核收(與臨床進(jìn)行溝通后),需要進(jìn)行相關(guān)的記錄說明。

涂片
記錄涂片結(jié)果,如染色方法、排列方式、觀察結(jié)果等。同時(shí),可根據(jù)項(xiàng)目自動(dòng)匹配默認(rèn)的陰性結(jié)果。
培養(yǎng)
標(biāo)本接種到對(duì)應(yīng)的培養(yǎng)基后,需要定時(shí)對(duì)平板的狀況進(jìn)行觀察,并且記錄觀察的結(jié)果。如果培養(yǎng)過程中發(fā)現(xiàn)需要分純或轉(zhuǎn)種,需要把分純或轉(zhuǎn)種的平板信息一并記錄。陽性血培養(yǎng)標(biāo)本需要進(jìn)行三級(jí)匯報(bào),周期長(zhǎng)內(nèi)容多,在進(jìn)行交接班的過程中可以通過查看過程記錄明確之前對(duì)應(yīng)內(nèi)容,指導(dǎo)下一步操作。在此過程中,對(duì)于關(guān)鍵節(jié)點(diǎn)也可通過高拍儀對(duì)菌落的生長(zhǎng)狀況,進(jìn)行留存。

菌落觀察
培養(yǎng)后,對(duì)菌落進(jìn)行觀察,過程記錄可記錄菌落特征(大小、顏色、表面、透明度、外形、高度、邊緣、光澤、硬度、溶血、氣味)和數(shù)量。
系統(tǒng)根據(jù)相關(guān)標(biāo)準(zhǔn)提供選項(xiàng),供操作者選擇,方便記錄觀察結(jié)果,同時(shí),確保過程記錄數(shù)據(jù)標(biāo)準(zhǔn)化、規(guī)范化;也可通過拍照,更加準(zhǔn)確的記錄實(shí)際情況。同時(shí)系統(tǒng)支持本院常見菌提示,可以根據(jù)觀察結(jié)果進(jìn)行初步的判斷。


藥敏記錄
對(duì)菌落進(jìn)行上機(jī)鑒定和藥敏試驗(yàn),記錄上機(jī)的儀器信息,以及使用的鑒定卡/藥敏卡的信息。儀器鑒定結(jié)果回傳后,可根據(jù)鑒定結(jié)果更新常見菌。同時(shí),在系統(tǒng)中,可看到相應(yīng)的藥敏報(bào)告,以及該標(biāo)本全部詳細(xì)的過程記錄,進(jìn)而進(jìn)行審核、打印。


Copyright ? 2022 上海科雷會(huì)展服務(wù)有限公司 旗下「智慧醫(yī)療網(wǎng)」版權(quán)所有 ICP備案號(hào):滬ICP備17004559號(hào)-5